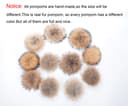
Thumbnail 7

We remain fully operational. Our teams are working around the clock to ensure your deliveries continue safely.
Servicios al cliente
Sobre nosotros
Copyright © 2025 Desertcart Holdings Limited

EASTER BARTHEWomen Cashmere Winter Slouchy Knit Beanie Hat with Real Fur Pom Pom Winter Beanie Knit Stocking Cap Ski Hat
L**
Great beanie!
Got so many compliments. It’s dual layer and super warm. The Pom Pom is a snap-on. When washing make sure to dry with the snap button facing down.
J**.
Very soft but Pom is misshapen
While the hat is super cute the Pom is misshapen so it kinda flips up at the end. This has made me conscious of wearing it.
E**S
precious !
You will not regret buying this hat, it is beautiful! the quality of the fabric and the leather excellent! I loved it
A**R
It's super soft and very flattering...
I purchased myself one of these a while ago - needless to say I was VERY HAPPY with my purchase. So much so, that I purchased it for my Best Friend of 50 + years. She loved it. The funny part of this story....she didn't know she was supposed to take the mesh off the fur pompom and she thought the hat was a gag gift. Well - after I told her to remove the mesh - she was hooked. The quality is very good, tight stitching, nice soft grey color and the REAL FUR pompom is attached by a snap. Making it possible to wash the fabric hat. It really is nice, warm and very fashionable. Don't hesitate - it really is an attractive, warm & versatile hat. I love it!!
R**E
Loved so much that I bought another!
I bought this hat in blue for a ski trip and loved it so much that I just ordered it in black. The quality is so nice and the cashmere feels great/isn’t itchy. The pom is perfect sized and amazingly soft! Highly recommend
S**N
Cashemere Real Fur Pom Pom Beanie
The quality is there, nice soft cashmere, real fur pom that is detachable with a snap. Fits good, Pom Pom is not too big or too small. Keeps my head nice and warm on those super cold days when you have to go out. Great value for the price.
Z**S
Very affordable for being cashmere. Great quality and thickness.
I am a big 6’4” thick guy and the beanie fits my big head perfectly. The cashmere blend is so soft and the beanie is super thick and warm - even after being stretched across my big head 😜. It covers my ears and forehead beautifully without looking too small or stretched.
M**O
Soft and elegant cashmere beanie
Great quality for the price...soft, elegant, and fits well. The pom snaps off for laundry, which is great
V**.
corect
je suis contente.
N**A
Super angenehm zu tragen!
Die Mütze ist der Wahnsinn. Qualität scheint dem Preis zu entsprechen. Kann ich nur weiterempfehlen.
Trustpilot
Hace 2 semanas
Hace 2 semanas
Hace 1 día
Hace 4 días